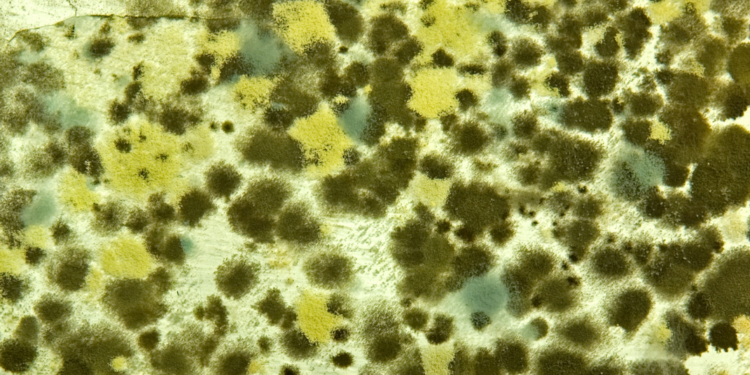
Prof. Dr. Ahmet Akçay : Küf sporlarına dikkat!

Küf mantarları; nemli ortamlara tutunan, sporları havada uçuşan küçük mantarlardır. Büyümek ve yayılım göstermek için hava, ideal sıcaklık, nem ve besine ihtiyaç duyarlar. Küf mantarları hava veya çürüyen bitkiler gibi dış alanlarda ve evin güneş görmeyen nemli alanlarında kendilerini gösterebilirler. Havanın görece daha sıcak ve nemli olduğu yaz mevsimi sonrasında ya da erken sonbahar başında spor sayısında çoğalma gözlemlenen küf mantarlarının; aynı zamanda gözle görülemeyen ve alerjik reaksiyonlara sebebiyet veren sporlar ürettiği bildirilmiştir.
Bireylerin hayatlarının spesifik dönemlerinde görülen alerjik semptomlar küf mantarı alerjisini akıllara getirebilir. Temel anlamda küf sporları büyüme ve üreme biçimleri odağından hayvanlardan ve bitkilerden daha farklıdır. Küf sporları, nem oranının yoğun olduğu bölgelerde, çiy formunda yayılım gösterebilir. Çocuk Alerji, Göğüs Hastalıkları Uzmanı, Alerji Astım Derneği Başkanı Prof. Dr. Ahmet Akçay, bazı insanlarda küf sporlarının solunmasına bağlı olarak alerjik reaksiyonların görülebileceğini söyledi. Prof. Dr. Ahmet Akçay; “Çok fazla küf cinsi olmasına karşın yalnızca birkaç düzine küf türünde alerjik semptomlar gelişmektedir. Bazı küf türleri, ağaçtan düşen yapraklar ve çürüyen kütükler üzerinde, çimenlerde gelişir. Yanlış bilinenin aksine her ne kadar havaların soğumasıyla polenler ölse de çoğu küf türü gelişmeye devam eder. Küfteki birincil alerjen, küf sporudur. Küf sporları havaya karışabildiklerinden dolayı bireylerin burunlarına da temas edebilir. Bu noktada alerjik reaksiyonlar tetiklenmektedir. Küf sporları, insan hayatında astım ve alerji ile ilişkilendirilebilir”.
Evinizde Küf Sporlarına Dikkat!
Sürekli olarak havada asılı kalan küf sporları alerjik semptomları tetikleyebilme potansiyeli taşır ve bu sporlar ıslak bir zemine yapıştıklarında ve küf genişlediğinde problemler daha ciddi boyutlara ulaşmaktadır. Evin içerisinde büyüyen küf genellikle neden olduğu saptanamamış su sızıntılarında ve çatı katlarında, bodrumlarda ve evin nemli bölgelerinde meydana gelebilmektedir. Prof. Dr. Ahmet Akçay, küfün özellikle nemli havalarda yoğunlaştığını ve evin içerisinde sıvası hasarlı olan duvarlarda, rutubetten yeşeren banyo karolarında, çürüyen mutfak dolaplarında, bitkilerin üzerinde ve nemlenen duvar kağıtlarında bulunabileceğini ifade etti. Ve ekledi: “Kendine özgü koku özelliğine sahip olan küf mantarları gözle görülemezler. Havada uçuşarak etrafa saçılır ve alerjik semptomların ortaya çıkmasına sebebiyet verebilir. Küf mantarları havanın nemli ve sıcak olduğu erken sonbahar döneminde artış gösterebildiği için bireyler, içerisinde bulunduğumuz şu günlerde daha dikkatli olmalılar”.
Bu Belirtiler Varsa Küf Alerjisine Dikkat!
Prof. Dr. Akçay, küf alerjisinin öteki üst solunum yolu alerjileri ile aynı belirtiler vasıtasıyla ortaya çıktığını ve küf alerjisinin sebebiyet verdiği alerjik rinit belirtilerinin; pullu ve kuru cilt yapısı, hapşırma, burun tıkanması veya akıntısı, geniz akıntısı ya da öksürük, burun ve boğaz kaşıntısı, göz yaşarması belirtilerini içerdiğini açıkladı. Küf alerjisinin belirti ölçeği bireyden bireye farklılık gösterebilmektedir. Temelde küf alerjisinin semptomları bireyden bireye farklılık gösterir ve senenin spesifik zamanlarında belirtileri şiddetlenebilir.
Küf Alerjisi Ender Vakalarda Gıda Alerjisine Benzetilebilir
Bireyin temel olarak küfe yönelik hali hazırda bir alerjisi mevcutsa, küf barındıran yiyeceklerin tüketimi besin alerjisi gibi görülen reaksiyonlara sebep olabilmektedir. Çoğu besinlerle alakalı, gıda bozulmuş gibi görünmeksizin saprofit şeklinde mantarlarla hafif kolonileşme ortaya çıkabilmektedir. Bu ve benzeri durumlarda besin maddesinin; tutarlılığı, şeker ve nem içeriği anahtar roldedir. Besinin tütsü haline getirilmesi ya da kurutulması oldukça önemli bir koruma yöntemidir. Bu noktada oluşabilecek risk; mantar öldürücü tedavinin olmamasına bağlı olarak organik ürünler kısmında sorunun git gide artmasıdır. Prof. Dr. Akçay; yağ, süt ürünleri, turunçgil veya çekirdekli meyveler, ekmek, yer fıstığı ve kurutulmuş meyveler gibi gıdaların genellikle küf sporlarını barındırdıklarının göz ardı edildiğinin altını çizdi.
Küf Mantarı Alerjisi Astımı Tetikliyor!
Küf alerjisi belli başlı durumlarda ciddi boyutlara ulaşıp beraberinde başka birtakım olumsuz durumların oluşmasına da neden olabilir. Prof. Dr. Ahmet Akçay, küf kaynaklı oluşabilecek birtakım komplikasyonları şöyle açıklamıştır: “Alerjik fungal sinüzit, sinüslerde iltihaplanmaya neden olan bir durumdur ve küf alerjisi bu durumu derinden etkiler. Öte yandan küf kaynaklı astım noktasında, küfe alerjisi olan bireylerde küf sporlarını solumak astım ataklarını tetikleyebilir. Bazı bireylerde küfe karşı maruziyet, astımın şiddetlenmesine sebebiyet verebilir. Tüm bunların yanı sıra ise alerjik fungal sinüzit; küf alerjisinin tetiklediği, sinüslerde iltihaplanmaya sebep olan bir durumdur”.
Küf Mantarı Alerjisinden Korunma Yolları
Prof. Dr. Ahmet Akçay, bireylerin yaşam alanlarında küf oluşumunu azaltmak adına birtakım yöntemlerden bahsetti:
- Bodrum katı gibi yerlerde oluşan yeraltı suyu ya da boru sızıntıları gibi nemli alanlar ortadan kaldırılmalıdır.
- Evlerde HEPA filtreli klima kullanmaya özen gösterilmelidir. HEPA filtre, küf sporlarını evin içerisine ulaşmadan evvel dış ortamda yakalayabilmektedir.
- Klima ve fırınların filtreleri düzenli olarak değiştirilmelidir.
- Tüm banyolar düzenli olarak havalandırılmalıdır ve duşun hemen ardından havayı kurutmak için havalandırma fanı devreye sokulmalıdır. Havalandırma fanının bulunmadığı durumlarda, duş alınırken bir pencere ya da kapı açık bırakılmalıdır.